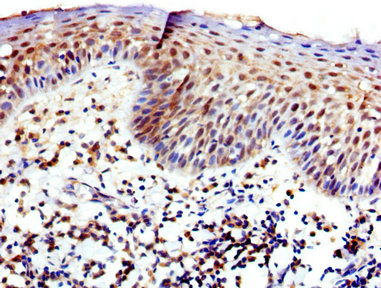

-
中文名稱:WAS兔多克隆抗體
-
貨號:CSB-PA025967LA01HU
-
規格:¥440
-
圖片:
-
Western Blot
Positive WB detected in: Colo320 whole cell lysate
All lanes: WAS antibody at 4.6µg/ml
Secondary
Goat polyclonal to rabbit IgG at 1/50000 dilution
Predicted band size: 53 kDa
Observed band size: 53 kDa -
IHC image of CSB-PA025967LA01HU diluted at 1:400 and staining in paraffin-embedded human tonsil tissue performed on a Leica BondTM system. After dewaxing and hydration, antigen retrieval was mediated by high pressure in a citrate buffer (pH 6.0). Section was blocked with 10% normal goat serum 30min at RT. Then primary antibody (1% BSA) was incubated at 4°C overnight. The primary is detected by a biotinylated secondary antibody and visualized using an HRP conjugated SP system.
-
Immunofluorescence staining of Hela cells with CSB-PA025967LA01HU at 1:150, counter-stained with DAPI. The cells were fixed in 4% formaldehyde, permeabilized using 0.2% Triton X-100 and blocked in 10% normal Goat Serum. The cells were then incubated with the antibody overnight at 4°C. The secondary antibody was Alexa Fluor 488-congugated AffiniPure Goat Anti-Rabbit IgG(H+L).
-
-
其他:
產品詳情
-
產品名稱:Rabbit anti-Homo sapiens (Human) WAS Polyclonal antibody
-
Uniprot No.:
-
基因名:
-
別名:Eczema thrombocytopenia antibody; IMD2 antibody; SCNX antibody; THC antibody; THC1 antibody; Thrombocytopenia 1 (X linked) antibody; U42471 antibody; Was antibody; WASp antibody; WASP_HUMAN antibody; Wiskott Aldrich syndrome (eczema thrombocytopenia) antibody; Wiskott Aldrich syndrome antibody; Wiskott Aldrich syndrome protein antibody; Wiskott-Aldrich syndrome protein antibody
-
宿主:Rabbit
-
反應種屬:Human
-
免疫原:Recombinant Human Wiskott-Aldrich syndrome protein (145-265AA)
-
免疫原種屬:Homo sapiens (Human)
-
標記方式:Non-conjugated
本頁面中的產品,WAS Antibody (CSB-PA025967LA01HU),的標記方式是Non-conjugated。對于WAS Antibody,我們還提供其他標記。見下表:
-
克隆類型:Polyclonal
-
抗體亞型:IgG
-
純化方式:>95%, Protein G purified
-
濃度:It differs from different batches. Please contact us to confirm it.
-
保存緩沖液:Preservative: 0.03% Proclin 300
Constituents: 50% Glycerol, 0.01M PBS, pH 7.4 -
產品提供形式:Liquid
-
應用范圍:ELISA, WB, IHC, IF
-
推薦稀釋比:
Application Recommended Dilution WB 1:500-1:5000 IHC 1:200-1:500 IF 1:50-1:200 -
Protocols:
-
儲存條件:Upon receipt, store at -20°C or -80°C. Avoid repeated freeze.
-
貨期:Basically, we can dispatch the products out in 1-3 working days after receiving your orders. Delivery time maybe differs from different purchasing way or location, please kindly consult your local distributors for specific delivery time.
-
用途:For Research Use Only. Not for use in diagnostic or therapeutic procedures.
相關產品
靶點詳情
-
功能:Effector protein for Rho-type GTPases that regulates actin filament reorganization via its interaction with the Arp2/3 complex. Important for efficient actin polymerization. Possible regulator of lymphocyte and platelet function. Mediates actin filament reorganization and the formation of actin pedestals upon infection by pathogenic bacteria. In addition to its role in the cytoplasmic cytoskeleton, also promotes actin polymerization in the nucleus, thereby regulating gene transcription and repair of damaged DNA. Promotes homologous recombination (HR) repair in response to DNA damage by promoting nuclear actin polymerization, leading to drive motility of double-strand breaks (DSBs).
-
基因功能參考文獻:
- study indicates that anti-inflammatory macrophage function and mucosal immune tolerance require both WASP and DOCK8, and that IL-10 signalling modulates a WASP-DOCK8 complex PMID: 29725003
- A novel WASP mutation (I290T) was found in an X-linked neutropenia patient and in his heterozygous mother. This mutation was located in the GTPase-binding domain. PMID: 28956125
- In a model of sterile inflammation utilizing TLR4 ligation followed by ATP or nigericin treatment, inflammasome activation is enhanced in monocytes from WAS patients. PMID: 29146903
- Despite the lack of typical clinical manifestations of WAS, low expression of WASP could be associated with the pathogenesis of a subtype of inflammatory bowel disease patients. PMID: 29358862
- expression of WASP inversely correlates with BCR-ABL1 levels and the progression of the disease in Chronic myeloid leukemia patients. downregulation of WASP contributes to the resistance to apoptosis and to BCR-ABL1-induced tumorigenesis. PMID: 29022901
- The coverage and depth of WASP were extremely low. PMID: 28901403
- WIP residues 454-456 are the major contributor to WASp affinity, and residues 449-451 were found to have the largest effect upon WASp ubiquitylation and, presumably, degradation. PMID: 29215267
- Novel WASP mutations were found in two patients with X-linked thrombocytopenia and their families. PMID: 28641574
- High WASP expression is associated with lung cancer invasion. PMID: 28351346
- A Treg-specific role for WASP is required for prevention of Th2 effector cell differentiation and allergic sensitization to dietary antigens. PMID: 27643438
- WASP and SCAR drive pseudopod formation and are conserved in actin-filled pseudopod-based motility. PMID: 28473602
- Authors show that knock-down of WASp or expression of Y102F mutant of WASp decreases colony formation and in vivo tumor growth. Results show that WASp is a novel substrate of ALK and has a critical role in regulating invasiveness and oncogenesis of ALCL. PMID: 27694894
- this study describes an Iranian boy with Wiskott-Aldrich syndrome with a novel WASP mutation PMID: 26993433
- The inducible recruitment of WASp to the TCR-CD3 complex is partially dependent of tyrosine phosphorylation of Cd3e. PMID: 26342115
- retrospectively investigated the outcome of hematopoietic stem cell transplantation in a cohort of 24 patients with the X-linked thrombocytopenia phenotype and mutations in the WAS gene PMID: 25388447
- This suggests that N-WASP's failure to compensate for WASP in rescuing chemotaxis could be due to the absence of this I30 region. PMID: 26463123
- N-WASP is downregulated in clear cell renal cell carcinoma PMID: 25115631
- Studies indicate that mutations in the Wiskott-Aldrich syndrome protein (WASp) gene cause a continuum of clinical symptoms ranging from intermittent X-linked thrombocytopenia to full classical Wiskott-Aldrich syndrome (WAS). PMID: 26159751
- Platelet actin nodule formation is dependent on WASp and the ARP2/3 complex. PMID: 26028144
- conclude that tyrosine phosphorylation of WIP is a crucial regulator of WASP stability and function as an actin-nucleation-promoting factor PMID: 25413351
- WASP, RUNX1, and ANKRD26 genes are important for normal TPO signaling and the network underlying thrombopoiesis. PMID: 26175287
- The introduction of functional WASp by GT corrected the alterations of both central and peripheral B cell tolerance checkpoints. WASp plays an important role in the establishment and maintenance of B cell tolerance in humans. PMID: 26368308
- We describe two Malay patients with classical Wiskott-Aldrich Syndrome with two different mutations in the WASP gene PMID: 26277674
- we identify small ubiquitin-related modifier (SUMO)ylation as a novel posttranslational modification of WASp PMID: 26261240
- A total of 60 unique WAS mutations were identified in Chinese patients, including 20 novel mutations and 8 hotspots, from 75 unrelated families with a total of 81 affected members. PMID: 25931402
- studies discovered that HMGB1 suppressed phosphorylation, nuclear translocation, and activation of CREB, by inhibiting nuclear translocation of PKA catalytic subunit PMID: 25277185
- data suggest that missense mutations WASPRL46P or WASPRA47D affect the activity of WASP in T cell chemotaxis probably by affecting the turnover of the protein. PMID: 25200405
- An indispensable relationship between nuclear-WASp- and hSWI/SNF-complexes in gene activation and molecular distinctions in TH cells that might contribute to disease severity in the X-linked thrombocytopenia/Wiskott-Aldrich syndrome clinical spectrum. PMID: 25253772
- Data indicate the WASp-interacting protein (WIP)-Wiskott-Aldrich syndrome protein (WASp) interaction in the regulation of actin-dependent processes. PMID: 24962707
- WASp and WAVE2 differ in their dynamics and their associated proteins PMID: 25342748
- WAS gene mutation is associated with X-linked thrombocytopenia in three males with normal sized platelets. PMID: 25154619
- WASP deficiency perturbs the homeostasis of B-cell compartment in humans. PMID: 24369837
- Data indicate that mycolactone analogues bind Wiskott-Aldrich syndrome proteins (WASP} with IC50 in the 50-10 muM range. PMID: 25158122
- These findings support a contributory role for defective Breg cells in the development of WAS-related autoimmunity PMID: 24945741
- study unveils an ARP2/3:VCA-independent function of nuclear-WASp in TH1 gene activation that is uncoupled from its cytoplasmic role in actin polymerization. PMID: 24872192
- Pro373Ser mutation reduces Tyr291 phosphorylation and prevents conformational changes required for WASP activity in chemotaxis and T-cell activation. PMID: 24440360
- Missense mutation in the WAS gene is associated with intermittent X-linked thrombocytopenia. PMID: 24115682
- We conclude that WASp function restricts TGF-b1 secretion in a Cdc42- and Src family kinase-dependent manner and independently of actin assembly PMID: 24133214
- We present two cases of WAS in neonates with WAS gene mutations PMID: 23301916
- Dedicator of cytokinesis 8 interacts with talin and Wiskott-Aldrich syndrome protein to regulate NK cell cytotoxicity. PMID: 23455509
- Data indicate that slit2N alters the localization and binding of Robo1 to WASp and LSP1 in HIV-1-gp120-treated immature dendritic cells (iDCs). PMID: 23119100
- Report five previously reported mutations and six novel mutations in WASP gene in Iranian Wiskott-Aldrich patients. PMID: 23264413
- this is the first report describing TTP in WAS patients with novel mutation in the WASP gene. PMID: 23237501
- Despite mediating enhanced actin polymerization, EVH1 missense-mutated human proteins did not function fully in mouse cells, even when overexpressed. Mutant protein retention in podosomes was impaired & associated with low WASp Tyr phosphorylation. PMID: 23160469
- study describes that both N-WASp and WASp participate in the inhibition of NK-cell chemotaxis in response to NKG2D WASp engagement, and that this effect is not dependent on the regulation of F-actin dynamics PMID: 22585739
- WASP-deficient T cells migrated in a normal proportion towards CXCL12, CCL19 and CCL21, but displayed an increased adhesion and elongation on ICAM-1 PMID: 22804504
- data suggest that regulated degradation of activated WASp might be an efficient strategy by which the duration and localization of actin rearrangement and the intensity of T-cell activation are controlled. PMID: 22665495
- The wild-type WASp, but not the mutant restored adhesion capacity, spreading morphology, and cytoskeletal reorganization. PMID: 22311461
- Mutation in WASP gene is associated with Wiskott-Aldrich syndrome and X-linked thrombocytopenia. PMID: 22038941
- the c.273+11dup change within the WAS gene was observed in patients showing symptoms consistent with the Wiskott-Aldrich syndrome; concluded that the presence of the additional C in the WAS gene is a functionally neutral polymorphism PMID: 21711396
顯示更多
收起更多
-
相關疾病:Wiskott-Aldrich syndrome (WAS); Thrombocytopenia 1 (THC1); Neutropenia, severe congenital, X-linked (XLN)
-
亞細胞定位:Cytoplasm, cytoskeleton. Nucleus.
-
組織特異性:Expressed predominantly in the thymus. Also found, to a much lesser extent, in the spleen.
-
數據庫鏈接:
Most popular with customers
-
-
YWHAB Recombinant Monoclonal Antibody
Applications: ELISA, WB, IHC, IF, FC
Species Reactivity: Human, Mouse, Rat
-
-
-
-
-
-